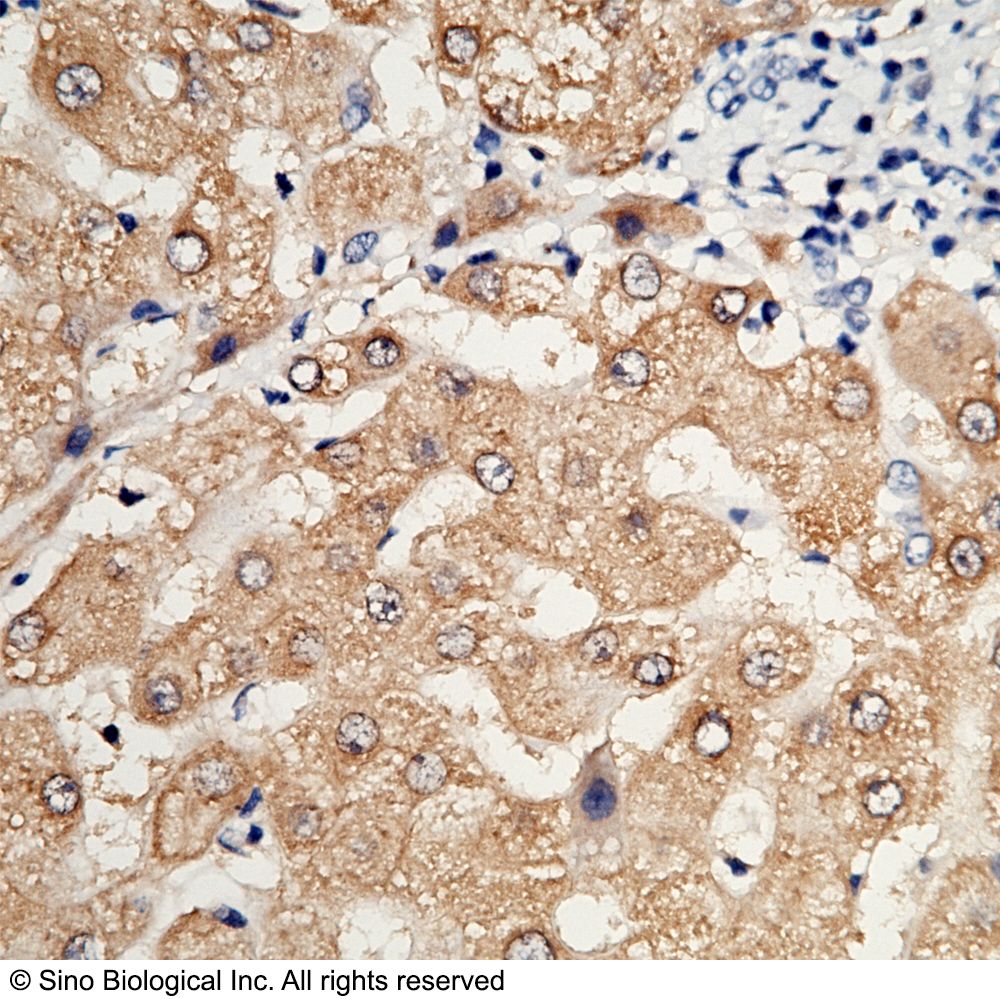
产品封面图

相关产品推荐更多 >
万千商家帮你免费找货
0 人在求购买到急需产品
- 详细信息
- 文献和实验
- 技术资料
- 规格:
100 µL
HAGH / GLO2 / Glyoxalase II 兔多抗(产品说明)
抗体种属:Human
抗体靶点:HAGH
抗体应用:WB,ELISA,IHC-P,IP
抗原货号:12146-H08E
抗原描述:Recombinant Human HAGH / GLO2 / Glyoxalase II protein (Catalog#12146-H08E)
抗体宿主:Rabbit
抗体Ig类型:Rabbit IgG
抗体纯化方法:Protein A & Antigen Affinity
抗体制备:Produced in rabbits immunized with purified, recombinant Human HAGH / GLO2 / Glyoxalase II (rh HAGH / GLO2 / Glyoxalase II; Catalog#12146-H08E; Q16775-2; Met 1-Asp 260). HAGH / GLO2 / Glyoxalase II specific IgG was purified by Human HAGH / GLO2 / Glyoxalase II affinity chromatography.
抗体特异性:Human HAGH / GLO2 / Glyoxalase II
抗体保存:This antibody can be stored at 2℃-8℃ for one month without detectable loss of activity. Antibody products are stable for twelve months from date of receipt when stored at -20℃ to -80℃. Preservative-Free. Avoid repeated freeze-thaw cycles.
风险提示:丁香通仅作为第三方平台,为商家信息发布提供平台空间。用户咨询产品时请注意保护个人信息及财产安全,合理判断,谨慎选购商品,商家和用户对交易行为负责。对于医疗器械类产品,请先查证核实企业经营资质和医疗器械产品注册证情况。
文献和实验1, Zhang D, et al. Lysine L-lactylation is the dominant lactylation isomer induced by glycolysis.Nature chemical biology, PubMed ID: 39030363
技术资料暂无技术资料 索取技术资料